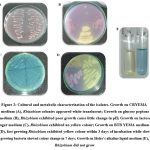

Introduction
The population in the world has increased substantially and expected to increase by 9.9 billion in 2050 mainly in developing countries1; hence, the food demand will also increase proportionately to maintain the healthy diet2-4. Pulse crops are considered as important food crops throughout the World due to higher protein content; thus, it becomes imperative to increase the production of pulse crops through sustainable agriculture to reduce the dependence on imports5-8. Bioinoculants promote the growth and yield of the pulse crops which have been used to supplement and/or replace chemical fertilizers9-13. Rhizobacteria efficiently colonize plant root and enhance their growth by diverse mechanisms such as hormones production, N2 fixation, mineral solubilization and antagonistic activities against anti-nutritional as well as pathogenic factors14,15.
Moreover pulses provide nutrients mainly N to the soil and makes them fertile and healthy. The bacterial colonization forms root nodules and this symbiotic association helps in biological nitrogen fixation (BNF) to make unavailable atmospheric nitrogen to available ammoniacal form for plants16-19. In agriculture around 80 % of BNF due to Rhizobiaceae bacteria, generally called as Rhizobia, includes six genera (Rhizobium, Bradyrhizobium, Mesorhizobium, Azorhizobium, Sinorhizobium, and Allorhizobium)20-22. The inoculation of Rhizobium increases the seed germination efficiency and thereby increase the yield of different pulse crops and shows their potential in plant growth promotion23-27. Hence, this study aimed to isolate, identify Rhiozobium and investigate PGP activities with an intention of using them for sustainable agriculture.
Materials and methods
The root nodules along with the rhizosphere soil was collected from the young and healthy seedlings of green gram plant in Sethu Bhaskara Agricultural College and Research Foundation (SBAC&RF), Karaikudi, Sivaganga, Tamil Nadu, India and the isolates were named as SBGR (Sethu Bhaskara Green gram Rhizobium).
Isolation of Rhizobium
Three healthy nodules were detached carefully from each of five plants chosen randomly. Surface sterilization was carried out using 70 % ethanol for 30 seconds then washed in sterile water for five times, followed by immersing in 0.1 % of HgCl2 for 30 seconds for complete removal of surface microorganisms and rinsed for 10 times in sterile water28. Then, surface sterilized nodules were transferred to a minimum quantity of sterile water and crushed with blunt end of sterilized glass rod to get nodule suspension. Later, the suspension was diluted and poured to sterile petriplates followed by the addition of yeast extract mannitol agar (YEMA) medium containing congo red29 and incubated for 24 to 48 h at 30 °C.
Characterization
Typical rhizobial colonies were recognized by their appearance on the YEMA plates and a total of 34 distinct isolates were selected and purified by several streaking, and preserved as glycerol stock for further characterization. Morphological characters such as macroscopic and microscopic observations were examined by the appearance of colony on CR-YEMA plate and gram staining. The following macroscopic characters such as colony colour, shape, texture, margin, opacity, and growth were observed30. For microscopic examination, gram reaction was performed by the preparation of smear followed by staining31. Twenty two isolates with gram negative and rod shaped cells were taken for biochemical methods including Methyl Red-Voges Prausker (MR-VP)32, amylase production33, cellulase production34 and citrate utilization35. Then, the isolates were characterized by the authentication test such as growth on CR agar36, bromothymol blue (BTB) reaction28, glucose peptone agar37, lactose assay38 and hofer’s alkaline assay39.
Screening of the isolates
The 22 isolates were estimated for PGP characters (mineral solubilization, indole acetic acid (IAA) production, HCN production and antagonistic activity). For mineral solubilization, the isolates were point inoculated on Pikovskaya’s40, Aleksandrov`s41, and Bunt and Rovira media42 separately for P, K, and Zn solubilization, and incubated for 5 days at 30 °C. The diameters of clear zones around the colonies were measured by solubilization index43. Indole production was performed qualitatively by point inoculation of bacterial isolates on trypton soya agar medium44 and incubated for 5 days at 30 °C. Then, a sterile whatman filter paper saturated with few drops of salkawski’s reagent was placed on bacterial growth. Appearance of pink color was marked as +, ++ and +++ for pale, moderate and dark colour for IAA production.
The bacterial isolates were streaked on Nutrient agar plate containing glycine45, then a sterile filter paper immersed in the solution of sodium carbonate and picric acid was placed on the top of petri-plate and incubated for 3-5 days. Formation of brown color was marked as +, ++ and +++ for pale, moderate and dark brown for HCN production. The bacterial isolates were tested to study their effect for antagonism against three important pulse pathogens viz., Colletotrichum sp., Macrophomina sp., and Aspergillus sp. Their mycelial disc was placed at one end of the potato dextrose agar plate and bacterium was streaked at opposite side of each plate46. The control plate was maintained with fungal mycelium alone and incubated at 30 ºC for 7 days and expressed as per cent inhibition using the formula, C-T/C x 100 where, C and T are the radial mycelia growth in control and treated plates47.
Plant assay
Among the twenty two isolates, eight (SBGR1, SBGR2, SBGR19, SBGR24, SBGR25, SBGR27, SBGR32, and SBGR34) were screened based on mineral solubilization, IAA, HCN production and antagonism taken for germination test. The bacterial isolates were inoculated in yeast extract manitol broth28 and allowed to grow for 3 days at 30 °C. Exponentially growing cells (1 OD@600nm) were inoculated to surface sterilized seeds. The surface sterilized seeds were treated with the isolates for 2 h, air-dried for 30 min. and twenty five seeds were placed over filter paper in sterile petri plates. The uninoculated seeds act as a control. Germination per cent was calculated by number of emerged seedlings/number of seeds sown x 10048. The shoot, root and total length along with fresh and dry weight of seedlings were observed on fifth day of inoculation. For dry matter production, whole seedlings were dried in hot air oven at 70-80 °C till the constant dry weight obtained and expressed as g per 25 seedlings.
Statistical analysis
All the data were subjected to statistical analysis with softwares, SPSS49 and Microsoft Excel for Windows 2007 add-ins with XLSTAT Version 2010.5.0550. Statistically significant differences between the treatments were analyzed using analysis of variance (ANOVA) and Duncan’s Multiple Range Test (DMRT) at 5 % significance level.
Results
Thirty four isolates, obtained from the nodules of green gram, were subjected to morphological characters.
Characterization
The macroscopic and microscopic characters were observed and presented in Table 1. Ninety per cent of the isolates were white to light pink in colour except SBGR19, SBGR26, and SBGR33. All the isolates being circular, translucent, gummy with entire margin and grown within 48 h were considered as fast growers except two (SBGR1, and SBGR2). Nearly twenty two isolates were gram negative rods which might be the Rhizobium and those were taken for biochemical analysis in the respective medium (Fig. 1). The results showed that many isolates were positive for indole production by the formation of cherry red colour except five isolates (SBGR5, SBGR6, SBGR8, SBGR9, and SBGR15). In MRVP test, half of the isolates were positive for MR test and were negative for VP test except 5 (SBGR3, SBGR5, SBGR6, SBGR8, and SBGR9) while few isolates (SBGR24, SBGR25, SBGR27, and SBGR28) showed positive for both tests. In citrate test, three quarters of isolates remained green in colour except eight (SBGR3, SBGR5, SBGR6, SBGR8, SBGR9, SBGR24, SBGR25, and SBGR34). Only very few isolates (SBGR1, SBGR19, SBGR24, SBGR25, SBGR32, SBGR33, and SBGR34) produced both amylase and cellulase enzymes.
Table 1: Morphological characters of the isolates.
| Isolates | Macroscopic observation | Microscopic observation | ||||||
| Colony colour | Shape | Texture | Opacity | Margin | Growth | Gram staining | Shape | |
| SBGR1 | LP | Circular | Gummy | Opaque | Entire | FG | – | Rod |
| SBGR2 | LP | Circular | Gummy | Opaque | Entire | FG | – | Rod |
| SBGR3 | White | Circular | Gummy | Translucent | Entire | FG | – | Rod |
| SBGR4 | White | Circular | Gummy | Translucent | Entire | FG | + | Cocci |
| SBGR5 | White | Circular | Gummy | Translucent | Entire | FG | – |
Rod |
| SBGR6 | MW | Circular | Gummy | Translucent | Entire | FG | – | Rod |
| SBGR7 | White | Circular | Gummy | Translucent | Entire | FG | + | Rod |
| SBGR8 | MW | Circular | Gummy | Translucent | Entire | FG | – | Rod |
| SBGR9 | Pink | Circular | Gummy | Translucent | Entire | FG | – | Rod |
| SBGR10 | White | Circular | Gummy | Translucent | Entire | FG | + | Rod |
| SBGR11 | White | Circular | Gummy | Translucent | Entire | FG | – | Rod |
| SBGR12 | White | Circular | Gummy | Translucent | Entire | FG | + | Rod |
| SBGR13 | White | Circular | Gummy | Translucent | Entire | FG | – | Rod |
| SBGR14 | White | Circular | Gummy | Translucent | Entire | FG | + | Rod |
| SBGR15 | MW | Circular | Gummy | Translucent | Entire | FG | – | Rod |
| SBGR16 | MW | Circular | Gummy | Translucent | Entire | FG | + | Cocci |
| SBGR17 | White | Circular | Gummy | Translucent | Entire | FG | – | Rod |
| SBGR18 | White | Circular | Gummy | Translucent | Entire | FG | + | Rod |
| SBGR19 | Red | Circular | Gummy | Translucent | Entire | FG | – | Rod |
| SBGR20 | White | Circular | Gummy | Translucent | Entire | FG | – | Rod |
| SBGR21 | LP | Circular | Gummy | Translucent | Entire | FG | + | Rod |
| SBGR22 | White | Circular | Gummy | Translucent | Entire | FG | + | Cocci |
| SBGR23 | LP | Circular | Gummy | Translucent | Entire | FG | + | Rod |
| SBGR24 | LP | Circular | Gummy | Translucent | Entire | FG | – | Rod |
| SBGR25 | LP | Circular | Gummy | Translucent | Entire | FG | – | Rod |
| SBGR26 | Red | Circular | Gummy | Translucent | Entire | FG | + | Rod |
| SBGR27 | LP | Circular | Gummy | Translucent | Entire | FG | – | Rod |
| SBGR28 | White | Circular | Gummy | Translucent | Entire | FG | – | Rod |
| SBGR29 | White | Circular | Gummy | Translucent | Entire | FG | – | Rod |
| SBGR30 | White | Circular | Gummy | Translucent | Entire | FG | + | Cocci |
| SBGR31 | White | Circular | Gummy | Translucent | Entire | FG | – | Rod |
| SBGR32 | LP | Circular | Gummy | Translucent | Entire | FG | – | Rod |
| SBGR33 | Red | Circular | Gummy | Translucent | Entire | FG | – | Rod |
| SBGR34 | LP | Circular | Gummy | Translucent | Entire | FG | – | Rod |
LP-light pink; MW-milky white; FG-Fast grower, – negative and + Positive.
 |
Figure 1: Biochemical characterization of the isolates. |
The presumptive tests of Rhizobium were conducted for all the twenty two isolates to examine their characters (Fig. 2). Ninety per cent of the isolates were white to pale pink in colour and did not absorb the red colour in CR medium. In BTB test many isolates changed their colour from deep green to yellow. These were considered as fast growers except few (SBGR17, SBGR19, SBGR25, SBGR27, and SBGR28). Thirty one isolates did not change the colour in Glucose peptone agar medium which were considered as positive and might be Rhizobium while three isolates (SBGR13, SBGR28, and SBGR33) produced yellow halo around the colony. Twenty nine isolates did not show yellow halo on lactose agar medium and considered as positive for Rhizobium except few (SBGR5, SBGR6, SBGR8, SBGR15, and SBGR33). Nearly half of the isolates did not grow on Hofer’s alkaline liquid medium which might be Rhizobium except 9 isolates (SBGR3, SBGR5, SBGR6, SBGR8, SBGR9, SBGR15, SBGR17, SBGR31, and SBGR33).
|
Figure 2: Cultural and metabolic characterization of the isolates. |
Screening of the isolates
All the isolates have solubilized phosphorous and highest solubilization index was observed in SBGR28 with 1.71 SI followed by SBGR2 (1.67 SI) while the least was observed in SBGR6 with 1.09 SI. The isolates SBGR8 and SBGR29 showed significantly highest solubilization index for K with 2.00 SI followed by SBGR11 (1.50 SI) while the least was observed in SBGR24 (1.08). Only half of the isolates solubilized zinc, in that SBGR2 had significantly higher solubilization index of 2.60 followed by SBGR28 (2.33 SI) (Table 2).
In qualitative assay of IAA and HCN, most of the isolates showed pink colour appearance by the addition of salkawski reagent and brown colour in picric acid filter paper. Rhizobium isolates tested for antagonistic activity towards three fungal pathogens (Colletotrichum sp., Macrophomina sp., and Aspergillus sp.) have been furnished in table 2 and fig. 3. The result showed only a very few strains such as SBGR1, SBGR19, SBGR24, SBGR25, SBGR27, SBGR32, and SBGR34 which have inhibited all the three tested pathogens. Among them, the isolate SBGR34 showed significantly highest inhibition of 55.6 %, 61.1 %, and 66.7 % for Colletotrichum sp., Macrophomina sp., and Aspergillus sp., respectively.
Table 2: Screening of the isolates for PGP activities.
|
Isolates |
Mineral solubilization | IAA | HCN | Antagonistic activity | ||||
| P | K | Zn | Colletotrichum sp. | Macrophomina sp. | Aspergillus sp. | |||
| SBGR1 | 1.20h | – | 1.80e | +++ | +++ | 50.0b | 44.4d | 55.6c |
| SBGR2 | 1.67b | 1.14h | 2.60a | ++ | +++ | 44.4c | – | 66.7a |
| SBGR3 | 1.20h | – | – | + | – | 33.3e | – | – |
| SBGR5 | 1.22f | 1.17g | – | – | – | 27.8f | – | – |
| SBGR6 | 1.09m | 1.40c | – | – | – | – | – | – |
| SBGR8 | 1.22f | 2.00a | – | – | – | – | – | – |
| SBGR9 | 1.14k | 1.20f | – | – | – | – | – | – |
| SBGR11 | 1.20h | 1.50b | – | ++ | – | 27.8f | – | – |
| SBGR13 | 1.14k | – | – | ++ | – | 27.8f | – | – |
| SBGR15 | 1.14k | 1.17g | 1.70g | – | – | – | 27.8e | – |
| SBGR17 | 1.25e | 1.20f | 1.33k | ++ | – | 44.4c | – | – |
| SBGR19 | 1.20h | – | 1.50i | +++ | +++ | 38.9d | 50.0c | 61.1b |
| SBGR20 | 1.33c | – | – | +++ | – | 33.3e | – | – |
| SBGR24 | 1.27d | 1.08j | 1.75f | +++ | +++ | 44.4c | 50.0c | 61.1b |
| SBGR25 | 1.12l | 1.11i | 1.86d | ++ | +++ | 55.6a | 44.4d | 66.7a |
| SBGR27 | 1.20h | 1.20f | 1.50i | +++ | +++ | 50.0b | 55.6b | 61.1b |
| SBGR28 | 1.71a | – | 2.33b | – | ++ | 33.3e | – | – |
| SBGR29 | 1.20h | 2.00a | – | + | + | 50.0b | – | – |
| SBGR31 | 1.19i | – | – | +++ | – | 27.8f | – | – |
| SBGR32 | 1.21g | 1.25e | 1.60h | ++ | ++ | 38.9d | 55.6b | 61.1b |
| SBGR33 | 1.15j | 1.17g | 2.09c | ++ | ++ | 27.8f | – | 46.7d |
| SBGR34 | 1.14k | 1.33d | 1.43j | +++ | +++ | 55.6a | 61.1a | 66.7a |
+, ++ and +++ for pale, moderate and dark colour.
 |
Figure 3: Antagonistic activity of Rhizobium isolates. |
Effect of Rhizobium inoculation on germination of lentil seed
Based on these PGP attributes, eight strains (SBGR1, SBGR2, SBGR19, SBGR24, SBGR25, SBGR27, SBGR32, and SBGR34) were chosen for plant study. These isolates were inoculated to the surface sterilized green gram seeds. Table 3 and fig. 4 showed the effect of rhizobial isolates on germination per cent. The less significant variation were observed among the treatments. The isolate, SBGR25 has high per cent germination of 98.0 % while uninoculated control showed least (84.0 %). The shoot, root and total height of germinated seedlings were measured and the result showed that the green gram seed treated with SBGR25 showed significantly highest shoot height of 10.3 cm followed by SBGR1 (7.95 cm). The root height of SBGR24 treatment showed highest with 6.35 cm and it was on par with SBGR25 treatment (6.00 cm). Similarly, the total plant height was significantly highest in SBGR25 with 16.6 cm followed by SBGR1 (13.2 cm). In all the cases, the untreated control showed least values of 4.35, 4.10 and 8.50 cm, respectively for shoot, root, and total plant heights. The fresh weight of SBGR25 showed highest value of 5.60 g and was on par with SBGR1 (5.54 g) and the least being observed in SBGR19 (4.25 g) while the dry weight was highest in SBGR2 (0.59 g) at par with SBGR25 (0.58 g).
Table 3: Effect of Rhizobium on germination and seedling growth of green gram.
| Treatments | Germination percentage | Shoot height (cm) | Root height (cm) | Plant height (cm) | Fresh weight (g) | Dry weight (g) |
| Control | 84.0 (±4.00)b | 4.35 (±0.15)f | 4.10 (±0.10)d | 8.50 (±0.25)d | 4.92 (±0.20)ab | 0.54 (±0.02)ab |
| SBGR1 | 94.0 (±6.00)ab | 7.95 (±0.05)b | 5.20 (±0.20)b | 13.2 (±0.25)b | 5.54 (±0.15)a | 0.44 (±0.00)c |
| SBGR2 | 90.0 (±6.00)ab | 7.80 (±0.10)bc | 4.55 (±0.15)cd | 12.4 (±0.25)bc | 4.95 (±0.05)ab | 0.59 (±0.05)a |
| SBGR19 | 92.0 (±4.00)ab | 7.20 (±0.10)de | 4.60 (±0.10)cd | 11.8 (±0.20)c | 4.25 (±0.20)d | 0.50 (±0.03)b |
| SBGR24 | 96.0 (±4.00)ab | 6.70 (±0.20)e | 6.35 (±0.10)a | 12.7 (±0.30)bc | 4.46 (±0.05)c | 0.45 (±0.01)c |
| SBGR25 | 98.0 (±2.00)a | 10.3 (±0.15)a | 6.00 (±0.15)a | 16.6 (±0.30)a | 5.60 (±0.08)a | 0.58 (±0.04)a |
| SBGR27 | 94.0 (±2.00)ab | 7.40 (±0.10)cd | 4.90 (±0.20)bc | 12.3 (±0.30)bc | 4.90 (±0.10)ab | 0.56 (±0.01)ab |
| SBGR32 | 86.0 (±2.00)ab | 7.55 (±0.25)bcd | 4.55 (±0.15)cd | 12.1 (±0.40)bc | 4.80 (±0.05)b | 0.45 (±0.01)c |
| SBGR34 | 94.0 (±2.00)ab | 7.30 (±0.20)cd | 4.55 (±0.25)cd | 11.9 (±0.45)c | 4.59 (±0.08)c |
0.50 (±0.02)b |
Values are mean ± SE (n=3) and within each row, values followed by same letters are not significantly different from each other according to DMRT (p≤0.05).
 |
Figure 4: Effect of Rhizobium isolates on seed germination and growth. |
Discussion
The atmospheric nitrogen is not readily available to plants because of its inert nature. The triple bond between two N molecules of atmospheric N2 must be broken for converting it to available form and bind with C, H, and O to form the building blocks of living organisms, for example, nucleotides, amino acids and proteins51. Therefore, nitrogen fixation is essential for agriculture52. The ability to reduce atmospheric N is restricted only to diazotrophs and a few diazotrophic microorganisms live in a symbiotic relationship with legume plants (Rhizobium), non-legumes (Frankia), waterfern, cycads and angiosperms (Nostoc), and also free living bacteria in the soil (Azotobacter)53. The inoculation of Rhizobium increases the plant growth promotion by increasing seed germination, shoot-root length; plant growth parameters thus ultimately increase the yield of the crops24,26,27. In this study, the Rhiozobium was isolated from the nodules of green gram and investigated for their PGP activities.
Isolation of root nodule bacteria
Rhizobium have been isolated from many pulse crops such as green gram, black gram, cow pea and faba bean54-57 and here, we isolated 34 strains from green gram.
Characterization of Rhizobium
Phenotypically, many strains develop colony within 2-3 days and would not absorb the indicator, congo red and remain white, translucent, glistening, elevated and comparatively smaller. These characters were similar to Rhizobium as reported earlier58. Several biochemical tests such as methyl red, and Voges Proskauer test, citrate utilization, indole, gelatinase activity, and starch hydrolysis were conducted as described by researcher59. Similarly, the present study carried IMViC tests (Fig. 1), which showed that the medium remains red in colour after the inoculation followed by incubation for MR test and changed to yellow for VP test for many isolates. Many strains showed positive result for Rhizobium in Simmon’s citrate agar medium.
In cultural and metabolic characterization, among twenty two isolates, nineteen were considered as positive for Rhizobium. Hence, they did not change colour in Glucose peptone medium. Similarly, no growth was found in Hofer’s alkaline liquid medium for the following thirteen isolates viz., SBGR1, SBGR2, SBGR11, SBGR13, SBGR19, SBGR20, SBGR24, SBGR25, SBGR27, SBGR28, SBGR29, SBGR32, and SBGR34. Therefore these were considered as positive and a few evidences also showed that these characters confirm the Rhizobium spp38.
Screening of the isolates
The mineral solubilization of SBGR2, SBGR15, SBGR17, SBGR24, SBGR25, SBGR27, SBGR32, SBGR33, and SBGR34 showed that these have solubilized all the ions tested (P, K and Zn). The phosphorous solubilization of SBGR28 isolate had the highest solubilization index of 1.71 followed by SBGR2 (1.67). SBGR8 and SBGR29 isolates showed potassium releasing ability with 2.00 SI while SBGR2 showed highest zinc solubilization index of 2.60. The P and Zn solubilization was observed in R. radiobacter LB2 and this strain showed highest zinc solubilization of 2.6 zsi (zinc solubilization index) which enhanced the yield of lettuce crop even in saline conditions60. Few scientists also observed the dissolution of potassium from gluconite ore by R. leguminosarum (25.88 %), and R. rhizogenes (23.60 %)61.
IAA production was qualitatively estimated for these strains and the results showed the formation of pink colour colonies on trypton soya agar medium when added with salkawski reagent. Few reports evaluated the effect of R. leguminosarum bv. trifolli strain E-11 on rice by growth due to production of IAA62-64 and cytokinin where R. radiobacter LB2 produced high amount of IAA (110.7 μg ml-1)60.
Rhizobia has the ability to inhibit soil-borne pathogens such as Fusarium, Sclerotium, Macrophomina, and Rhizoctonia 65-67 by the production of compounds such as antibiotics, mycolytic enzymes, HCN, and siderophore. Here also, HCN production was observed qualitatively on glycine nutrient agar medium. Nearly half of the isolates showed brown colour in picric acid filter paper. Dual culture technique for pathogenecity test revealed that the isolate SBGR34 has significantly highest inhibition of 55.6, 61.1, and 66.7 % for Colletotrichum sp., Macrophomina sp., and Aspergillus sp., respectively followed by SBGR25 (55.6, and 66.7 % for Colletotrichum sp., and Aspergillus sp., respectively).
Plant assay
In the germination assay, SBGR25 treated seeds have significantly high per cent germination of 98.0 %. Few reports found that Bradyrhizobium strains (AHR-2, AHR-5, and AHR-6) significantly increased the germination by 26 % along with higher seedling biomass (80-90 % increases) in ground nut crop68. The treatment, SBGR25 showed significantly highest shoot, total height and fresh weight with 10.3 cm, 16.6 cm and 5.60 g, respectively. Many reports have concluded that the Rhizobium inoculation enhance the shoot and root length, dry matter production and the yield of crop plants69-75.
The present study reports that based on morphological, biochemical and cultural characteristics, the root nodule bacteria isolated from green gram nodules might be Rhizobium. Most of these strains have PGP traits such as mineral solubilisation, production of IAA and HCN along with antagonistic property against pathogens can enhance the plant growth and promotion. It was evident in germination test that the strain SBGR25 showed highest plant attributes and suggest that this strain may be used as promising bio-inoculant to increase the yield of pulse crops. Further, molecular identification of isolates is needed for their confirmation as Rhizobium and also field studies are required for their evaluation.
Acknowledgement
We cordially acknowledge the Principal, Dr. K. Karunanithi and the Chairman, Dr. Sethu Kumanan of Sethu Bhaskara Agriultural College and Research Foundation, Karaikudi, Sivaganga, Tamil Nadu, India 603 306 for providing all necessary support to complete the final year project work as in the B.Sc. (Hons.) Agri. course.
Funding Source
The authors declare that no funds, grants, or other support were received during the preparation of this manuscript.
Conflict of Interest
The authors declare no conflicts of interest.
Reference
- United Nations. World population prospects: the 2006 revision. New York, NY: United Nations Population Division. 2007.
- Gao Z, Yu X, Lee JY. Consumer demand for diet quality: Evidence from the healthy eating index. Aust J Agric Resour Econ. 2013;57(3):301-319.
- Dominguez-Viera ME, van den Berg M, Donovan J, Perez-luna ME, Ospina-rojas D, Handgraaf M. Demand for healthier and higher-priced processed foods in low-income communities: Experimental evidence from Mexico City. Food Qual Prefer. 2022;95:104362. https://doi: 1016/j.foodqual.2021.104362.
- Maitra S, Hossain A, Brestic M, Skalicky M, Ondrisik P, Gitari H, Brahmachari K, Shankar T, Bhadra P, Palai JB, Jena J. Inter-cropping—a low input agricultural strategy for food and environmental security. 2021;11(2):343.
- Gan YT, Zentner RP, Campbell C, Biederbeck VO, Selle F, Lemke R. Conserving soil and water with sustainable cropping systems: Research in the semiarid Canadian Prairies. Paper presented at: 12th ISCO Conference. http://www.tucson.ars.ag.gov/isco/isco12/VolumeIII/. 2002.
- Ebert AW. Potential of underutilized traditional vegetables and legume crops to contribute to food and nutritional security, income and more sustainable production systems. Sustainability. 2014;6(1):319-335. https://doi: 10.3390/su6010319.
- Pooniya V, Choudhary AK, Dass A, Bana RS, Rana KS, Rana DS, Tyagi VK, Puniya MM. Improved crop management practices for sustainable pulse production: An Indian perspective. Indian J Agric Sci. 2015;85 (6):747–58.
- Jallinoja PT, Niva MH, Latvala TT. Future of sustainable eating? Futures. 2016;83:4-14. https://doi: 10.1016/j.futures.2016.03.006.
- Santoyo G, Orozco-Mosqueda MC, Govindappa M. Mechanisms of biocontrol and plantgrowth-promoting activity in soil bacterial species of Bacillus and Pseudomonas: a review. Biocontrol Sci Tech. 2012;22:855–872.
- Shen Z, Zhong S, Wang Y, Wang B, Mei X, Li R, Ruan Y, Shen Q. Induced soil microbial suppression of banana fusarium wilt disease using compost and biofertilizers to improve yield and quality. Eur J Soil Biol. 2013;57:1-8.
- Vurukonda SSKP, Giovanardi D, Stefani E. Plant Growth Promoting and Biocontrol Activity of Streptomyces spp. as Endophytes. Int J Mol Sci. 2018;19(4):952. https://doi.org/10.3390/ijms19040952.
- Mahmud AA, Bhojiya AA. Biofertilizers: A Nexus between soil fertility and crop productivity under abiotic stress. Current Research in Environmental Sustainability. 2021;3:1-10.
- Daniel AI, Fadaka AO, Gokul A, Bakare OO, Aina O, Fisher S, Burt AF, Mavumengwana V, Keyster M, Klein A. Biofertilizer: The future of food security and food safety. Microorganisms. 2022;10(6)1220. https://doi.org/10.3390/ microorganisms10061220.
- Deshwal VK, Singh SB, Kumar Pand Chubey A. Rhizobia unique plant growth promoting rhizobacteria: A Review. Int J Life Sci. 2013;2(2):74-86.
- Dakora FD, Viviene N, Matiru A, Kanu AS. Rhizosphere ecology of lumichrome and riboflavin, two bacterial signal molecules eliciting developmental changes in plant. Front Plant Sci. 2015;6:700. https://doi. 10.3389/fpls.2015.00700.
- Giller K, Cadisch G. Future benefits from biological nitrogen fixation: An ecologicalpproach to agriculture. Plant and Soil. 1995;174:255-277. https://doi:10.1007/BF00032251.
- Shokri D, Emtiazi G. Indole-3-Acetic Acid (IAA) Production in Symbiotic and Non-Symbiotic Nitrogen-Fixing Bacteria and its Optimization by Taguchi Design. Curr Microbiol. 2010; 61:217-25. https:// doi:10.1007/s00284-010-9600-y.
- Rascio N, La Rocca N. Biological Nitrogen Fixation. Encyclopedia of Ecology, 2013;2: 264-279.
- Ibny FY, Jaiswal SK, Mohammed M, Dakora FD. Symbiotic effectiveness and ecologically adaptive traits of native rhizobial symbionts of Bambara groundnut (Vigna subterranea Verdc.) in Africa and their relationship with phylogeny. Sci Rep. 2019;9: 12666. https://doi: 10.1038/s41598-019-48944-1.
- Phillips DA, Joseph CM, Yang GP, Martínez-Romero E, Sanborn JR, Volpin H. Identification of lumichrome as a Sinorhizobium enhancer of alfalfa root respiration and shoot growth. Proc Natl Acad Sci USA. 1999;96(22):12275-12280. https://doi: 10.1073/pnas.96.22.12275.
- Stajkovi´c O, Deli´c D, Joši´c D, Kuzmanovi´c D, Rasuli´c N, KneŽevi´c-Vukˇcevi´c J. Improvement of common bean growth by co-inoculationwith Rhizobium and plant growth-promoting bacteria. Rom Biotechnol Lett. 2011;6:5919–5926.
- Siqueira AF, Ormeño-Orrillo E, Souza RC, Rodrigues EP, Almeida LGP, Barcellos FG, Batista JSS, Nakatani AS, Martinez-Romero E, Vasconcelos ATR, Hungria M. Comparative genomics of Bradyrhizobium japonicum CPAC 15 and Bradyrhizobium diazoefficiens CPAC 7: elite model strains for understanding symbiotic performance with soybean. BMC Genomics. 2014;15(1), 420. https://doi: 10.1186/1471-2164-15-420.
- Prithiviraj B, Zhou X, Souleimanov A, Kahn W, Smith D. A host-specific bacteria-to-plant signal molecule (Nod factor) enhances germination and early growth of diverse crop plants. Planta. 2003;216(3):437-445. https://doi: 10.1007/s00425-002-0928-9.
- Kidaj D, Skorupska A. Nod factors stimulate seed germination and promote growth and nodulation of pea and vetch under competitive conditions. Microbiol Res. 2012;167(3):144-150.
- Kozieł M, Gębala B, Martyniuk S. Response of soybean to seed inoculation with Bradyrhizobium japonicum and with mixed inoculants of japonicum and Azotobacter chroococcum. Pol J Microbiol. 2013;62(4):457-460.
- Martyniuk S, Kozieł M, Gałązka A. Response of pulses to seed or soil application of rhizobial inoculants. Ecol Chem Eng S. 2018;25(2):323-329. https://doi: 10.1515/eces-2018-0022.
- Jaiswal SK, Mohammed M, Ibny FYI, Dakora FD. Rhizobia as a source of plant growth-promoting molecules: potential applications and possible operational mechanisms. Front Sustain Food Syst. 2021;4:619676. https://doi.org/10.3389/fsufs.2020.619676.
- Somasegaran P, Hoben HJ. Handbook for Rhzobia: Methods in legume-Rhizobium Springer-Verlag Publisher., New York, 1994:450.
- Vincent JM. A manual for the practical study of the root nodule bacteria. Oxford: Blackwell Scientific Publications. 1970.
- Muthini M, Maingi JM, Muoma JO, Amoding A, Mukaminega D, Osoro N, Mgutu A, Ombori O. Morphological assessment and effectiveness of indigenous rhizobia isolates that nodulate vulgaris in water hyacinth compost testing field in Lake Victoria basin. Br J Appl Sci Technol. 2014;4(5):718-738. https://doi. 10.9734/BJAST/2014/5757.
- Somasegaran P, Hoben HJ. Methods in legume Rhizobium University of Hawaii NifTAL Project, Paia, Hawaii, 1985:367.
- Seeley M, Vandermark S. Isolation and identification of some PPFMS bacterial isolates and their potentiality as biofertilizers and biocontrol agents to Rhizoctonia solani. Journal of Agricultural Chemistry and Biotechnology. 1981;4:79-85.
- Eckford MD. Thermophillic bacteria in milk. Am J Hyg. 1927;7:200-201.
- Aneja KR. Experiments in microbiology, plant pathology, tissue culture and mushroom cultivation. 2nd edition, New Age International Publishers, New Delhi, India. 1996.
- Simmons JS. A culture method for differentiating organisms of typhoid colour aerogenes group and for isolation of certain fungi. J Infect Dis. 1976;39:209.
- Vincent JM. Root-nodule symbiosis with Rhizobium. In: Quispel A (Ed.). Biology of Nitrogen Fixation. North-Holland Publishing Co., Amsterdam. 1974.
- Kleczkowska J, Nutman PS, Skinner FA, Vincent The identification and classification of Rhizobium. In: Gibbs BM,Shapton DA (eds). Identification Methods for Microbiologists, Part B. Academic Press, London. 1968.
- Shahzad F, Shafee M. Isolation and biochemical characterization of rhizobium meliloti from root nodules of Alfalfa (Medico sativa). Journal of Animal and Plant Sciences. 2012;22(2):522-524.
- Hofer AW. A characterization of Bacterium radiobacter. J Bacteriol. 1941;41:193-224.
- Sperber JI. The incidence of apatite-solubilizing organisms in the rhizosphere and soil. Aust J Agric Res. 1958;9:778–781.
- Aleksandrov VG, Blagodyr RN, Ilev IP. Liberation of phosphoric acid from apatite by silicate bacteria. Mi-krobiolohichnyiZhurnal (Kiev). 1967;29:111–114.
- Bunt JS, Rovira AD. Microbiological studies of some subantarctic soils. J Soil Sci. 1955;6(1):119-128.
- Srivastava S, Yadav KS, Kundu BS. Prospects of using phosphate solubilizing Pseudomonas as biofungicide. Indian J Microbiol. 2004;44:91- 94.
- Hamza TA, Alebejo AL. Isolation and characterization of rhizobia from rhizosphere and root nodule of Cowpea, elephant and lab plants. IJNRIS. 2017;4:1–7.
- Bakker AW, Schippers B. Microbial cyanide production in the rhizosphere in relation to potato yield reduction and pseudomonas spp-mediated plant growth-stimulation. Soil Biol Biochem. 1987; 19, 451-457. https://doi.org/10.1016/0038-0717(87)90037-X.
- Sariah M. Potential of Bacillus as a biocontrol agent for anthracnose fruit rot of chilli. Mal Appl Biol. 1994;23:53-60.
- Skidmore AM, Dickinson CM. Colony interactionsand hyphal interference between Sepatoria nodorum andphylloplane fungi. Trans Br Mycol Soc. 1976;66:57 -64.
- Islam S, Akanda AM, Prova A, Islam MT, Hossain MM. Isolation and Identification of Plant Growth Promoting Rhizobacteria from Cucumber Rhizosphere and Their Effect on Plant Growth Promotion and Disease Suppression. Front Microbiol. 2016;6:1360. https://doi: 10.3389/fmicb.2015.01360.
- Kirkpatrick LA, Feeney BC. An edition of A simple guide to SPSS for Windows. Belmont, CA:Wadsworth. 2005.
- Statistical Software for Excel. 2007. https://www.xlstat.com
- Kitadai N, Maruyam S. Origins of building blocks of life: A review. Geoscience Frontiers. 2018;9(4):1117-1153.
- Hajjawi OS. Ribonucleic acid (RNA) biosynthesis in human cancer. Cancer Cell Int. 2015;15:22. https://doi: 10.1186/s12935-015-0167-3.
- Santi C, Bogusz D, Franche C. Biological nitrogen fixation in non-legume plants. Ann Bot. 2013;111(5):743-767. https://doi: 10.1093/aob/mct048.
- Khurana A, Poonam S, Sharma P. Variety and Rhizoium strain interaction in Lentil. LENS Newsletter. 1995;22:13–5.
- Zahran Rhizobium-legume symbiosis and nitrogen fixation under severe conditions and in an arid climate. Microbiol Mol Biol Rev. 1999;63(4):1-5.
- Malik MA, Hussain S, Warraich EA, Habib A, Ullah S. Effect of seed inoculation and phosphorus application on growth, seed yield and quality of mungbean (Vigna radiate) CV. NM-98. Int J Agric Biol. 2002;4:515–6.
- Hayat R, Ali S, Khan FS. Effect of nitrogen and Rhizobium inoculation on yield, N up take and economic of mungbean. Int J Agric Biol. 2004;6:547–51.
- Arora DR. The Text Book of Microbiology. New Delhi: CBS Publisher, 2003:41-48.
- Lowe GH. The rapid detection of lactose fermentation in paracolon organism by demonstration of 6-D-galactosidase. J Med Lab Technol. 1962;19:21–25.
- Verma M, Singh A, Dwivedi DH, Arora NK. Zinc and phosphate solubilising Rhizobium radiobacter LB2 for enhancing quality and yield of loose leaf lettuce in saline soil. J Environ Sustain. 2020;3:209-218. https://doi.org/10.1007/s42398-020-00110-4.
- El-Barbary TAA, El-Badry MA. Solubilization of potassium from gluconite by microorganisms. Journal of Basic and Environmental Sciences. 2018;5:240-244.
- Yanni YG, Rizk RY, El-Fattah FKA, Squartini A, Corich V, Giacomini A, de Bruijn F, Rademaker J, Maya-Fores J, Ostrom P, Vega-Hernandez M, Hollingsworth RI, Martinez-Molina E, Mateos P, Velaquez E, Woperis J, Triplett E, Umali-Garcia M, Anarna JA, Rolfe BG, Ladha JK, Hill J, Mujoo R, Ng PK, Dazzo FB. The beneficial plant-growth promoting association of Rhizobium leguminosarum Trifolii with rice roots. Aust J Plant Physiol. 2001;28:845-870.
- Dazzo FB, Yanni YG, Rizk R, de Bruijn FJ, Rademaker J, Squartini A, Corich V, Mateos P, Martínez-Molina E, Velázquez E, Biswas JC, Hernandez RJ, Ladha JK, Hill J, Weinman J, Rolfe BG, Vega-Hernández M, Bradford JJ, Hollingsworth RI, Ostrom P, Marshall E, Jain T, Orgambide G, Philip-Hollingsworth S, Triplett E, Malik KA, Maya-Flores J, Hartmann A, Umali-Garcia M, Izaguirre-Mayoral ML. Progress in multinational collaborative studies on the beneficial association between Rhizobium leguminosarum bv. trifolii and rice. In: Ladha JK, Reddy PM eds The quest for nitrogen fixation in rice The Philippines, IRRI Press: Los Baños; 2000:167–189.
- Noel TC, Sheng C, Yost CK, Pharis RP, Hynes MF. Rhizobium leguminosarum as a plant growth promoting rhizobacterium: direct growth promotion of canola and lettuce. Can J Microbiol. 1996;42: 279–283.
- Arfaoui A, Sifi B, Boudabous A, El-Hadrami I, Cherif M. Identification of Rhizobium isolates possessing antagonistic activity against Fusarium oxysporum SP. Ciceris, The causal agent of Fusarium wilt of Chickpea. J Pl Pathol. 2006;88(1):67-75.
- Gachande BD, Khansole GS. Morphological, cultural and biochemical characteristics of Rhizobium japonicum syn and Bradyrhizobium japonicum of soybean. Biosci Discov. 2011;2:1-4.
- Pawar VA, Pooja RP, Bhosale AM, Chavan SV. Effect of Rhizobium on Seed Germination and Growth of Plants. J Acad Ind Res. 2014;3(2):84-88.
- Deshwal VK, Dubey RC, Maheshwari DK. Isolation of plant growth-promoting strains of Bradyrhizobium (Arachis) sp. with biocontrol potential against Macrophomina phaseolina causing charcoal rot of peanut. Curr Sci. 2003;84(3):443-448.
- Thakur AK, Panwar JDS. Effect of Rhizobium -VAM interactions on growth and yield in mungbean (Vigna radiata) under field conditions. Indian J Plant Pathol. 1995;38: 62-65.
- Sharma S, Upadhyay RG, Sharma CR, Rameshwar R. Response on growth, physiological parameters and yield of Vigna radiate L. Wilczek under rain fed and mid hill conditions of Himachal Pradesh. Indian J. Agric. Res. 2003;37(1): 52-55.
- Biswas P, Hosain D, Ullah M, Akter N, Bhuiya MAA. Performance of groundnut (Arachis hypogaea ) under different levels of bradyrhizobial inoculum and nitrogen fertilizer. SAARC J Agric. 2003;1:61–68.
- Rahman MA. Effect of calcium and Bradyrhizobium inoculation of the growth, yield and quality of groundnut (Arachis hypogaea). Bangladesh J Sci Indust Res. 2006;41:181–188.
- Brahmaprakash GP, Girisha HC, Navi V, Laxmipathy R, Hegde SV. Liquid Rhizobium inoculant formulations to enhance biological nitrogen fixation in food legumes. J Food Legumes. 2007;20(1):75–79.
- Delić D, Stajković-Srbinović O, Kuzmanović D, Rasulić N, Mrvić V, Andjelović S, Knežević-Vukčević J. Effect of bradyrhizobial inoculation on growth and seed yield of mungbean in Fluvisol and Humofluvisol. Afr J Microbiol Res. 2011;5(23):3946-3957.
- Kundu R, Jajati M, Aparajita M. Growth and Production Potential of Greengram (Vigna radiata) Influenced by Rhizobium Inoculation with Different Nutrient Sources. Int J Agric Environ Biotech. 2013;6(3):344-350.

